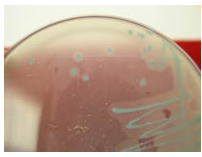
大肠杆菌在伊红美蓝上颜色_伊红美蓝鉴别大肠杆菌颜色变化_伊红美蓝鉴别大肠杆菌颜色变化

微生物检测涉及多行业和领域,也是食品领域的重要检测项目之一。菌落总数作为微生物检测的重要指标,大家在实际操作中,却常遇到难以分清微生物菌落、菌落总数检测不合格等令人苦恼的问题,本期我们针对这些问题给大家进行梳理总结,希望对大家有所帮助!
|01.常见微生物菌落形态图
|02.菌落特征比较总结
|03.菌落总数不合格原因与对策
一、常见微生物菌落形态图
细菌
金黄色葡萄球菌
1. 金黄色葡萄球菌在BP琼脂上典型特征

特征描述: 金黄色葡萄球菌呈圆形,表面光滑、凸起、湿润,直径 2-3mm 。灰黑色至黑色 ,有光泽,常有浅色(非白色)的边缘,周围绕以不透明圈(沉淀),其外常有一清晰带(卵磷脂环)。当用接种针触及菌落时具有黄油样粘稠感。有时可见到不分解脂肪的菌株,除没有不透明圈和清晰带外,其他外观基本相同。从长期贮存的冷冻或脱水食品中分离的菌落,其黑色常较典型菌落浅些,且外观可能较粗糙,质地较干燥。
2. 金黄色葡萄球菌在金黄色葡萄球菌显色培养基上典型特征

特征描述: 典型的金黄色葡萄球菌为灰黑色菌落,其外围有一不透明圈,本培养基用于直接鉴定金黄色葡萄球菌,如果在18-24小时没有出现典型菌落,需再培养18-24小时。有时金黄色葡萄球菌不显灰黑色,但其外围有一不透明圈。
3. 金黄色葡萄球菌在甘露醇高盐琼脂培养基上典型特征

特征描述: 金黄色葡萄球菌显黄色,其外围有一黄色的晕环。
大肠杆菌

1. 大肠杆菌在大肠杆菌/大肠菌群显色培养基上典型特征

特征描述: 大肠杆菌典型菌落为蓝色至紫色,大肠菌群为粉红色菌落,其它细菌为无色菌落。
2. 大肠杆菌O157菌在O157菌显色培养基上典型特征

特征描述: 典型O157:H7菌显紫色,大肠杆菌和大肠菌群显暗蓝色。
3.大肠杆菌在伊红美蓝琼脂(EMB)上典型特征

特征描述: 大肠杆菌典型菌落为蓝色至紫色,大肠菌群为粉红色菌落,其它细菌为无色菌落。
4.大肠杆菌在月桂基硫酸盐胰蛋白胨肉汤(LST)上典型特征

特征描述: 大肠杆菌分解乳糖产生气体 ,小倒管内收集有气泡。
沙门氏菌
1. 沙门氏菌在沙门氏菌显色培养基上典型特征

特征描述: 典型沙门氏菌显亮红色,大肠杆菌显蓝色绿色,枸橼酸杆菌显紫色,其它细菌显黄色或无色。
2.沙门氏菌在胆硫乳琼脂(DHL琼脂)上典型特征

特征描述:沙门氏菌在37℃培养22-24小时后,呈无色半透明有黑色中心或几乎全为黑色。有些菌株呈无色半透明。
3. 沙门氏菌在亚硫酸铋琼脂(BS琼脂)上典型特征

特征描述:沙门氏菌在37℃培养24-48小时后,呈棕褐色或灰色至黑色,有时有金属光泽,周围培养基呈棕色或黑色,有些菌株呈灰绿色,周围培养基不变或微变暗。
4.沙门氏菌在XLD琼脂上典型特征

特征描述:沙门氏菌在35℃培养24-48小时后,呈无色半透明有黑色中心或几乎全为黑色。
5. 沙门氏菌在SS琼脂上典型特征

特征描述: 沙门氏菌在 37 ℃ 培养18-24小时后,呈无色透明菌落有黑色中心。
6. 沙门氏菌在HE琼脂上典型特征

特征描述:沙门氏菌在37℃培养18-24时后,沙门氏菌、亚利桑那菌和变形杆菌为蓝绿色至蓝色、有或无黑色中心的菌落。
李斯特氏菌
1.单增李斯特氏菌在李斯特氏菌显色培养基上典型特征

特征描述: 单增李斯特氏菌37℃培养24-28小时,平板上出现蓝色菌落,菌落周围有一不透明环。绵羊李斯特氏菌37 ℃培养48小时,平板上出现蓝色菌落,菌落周围有一不透明环。西尔李斯特氏菌37℃培养24-48小时,平板上出现蓝色菌落,菌落周围没有不透明环。在食品检测中绵羊李斯特氏菌非常少见。
2.李斯特氏菌在PALCAM琼脂上曲型特征

特征描述:李斯特氏菌在35℃培养24-48小时后,灰绿色菌落。其外围有一黑色环。
蜡样芽胞杆菌
蜡样芽孢杆菌在MYP琼脂上典型特征

特征描述: 蜡样芽孢杆菌显白色 ,其外围有粉红色的晕环。
霉菌
霉菌在孟加拉红培养基上典型特征

特征描述: 霉菌在孟加拉红培养基上典型特征为灰色菌落,有黑色孢子。
酵母菌
1. 酵母菌在孟加拉红培养基上典型特征

特征描述: 酵母菌在孟加拉红培养基上典型特征为红色菌落。
2. 酵母菌在马铃薯葡萄糖琼脂上典型特征


特征描述: 酵母菌在马铃薯葡萄糖琼脂上在28 ℃培养48小时后,呈乳白色菌落,有突起。
二、菌落特征比较总结
外形特征:
细菌:湿润,粘稠,易挑起。
放线菌:干燥,多皱,难挑起,菌落较小,多有色素。
酵母菌:湿润,粘稠,易挑起,表面光华,比细菌的菌落大而厚。
霉菌:菌丝细长,菌落疏松成绒毛状、蜘蛛网状、棉絮状,无固定大小,多有光泽,不易挑起。
菌落特征:
细菌:一般形成较小的圆形菌落,颜色有白色、黄色等,表面光滑或不光滑。
放线菌:菌落背面有同心圆形纹路。这点可以和细菌菌落区分。
酵母菌:菌落为淡黄色,光滑伊红美蓝鉴别大肠杆菌颜色变化,半透明,比细菌菌落大。
霉菌:菌落大型,肉眼可见许多毛状物,棕色、青色等,可见黑色的分生孢子群。
三、菌落总数不合格原因与对策
菌落总数不合格(超标)的原因及其解决方案有哪些呢?下面我们以食品中菌落总数超标为例,从(人、机、物、法、环、流)六个方面角度来逐个分析。
(一)人员
食品生产、运输、销售的各个环节员工的不正确行为都有可能导致菌落总数超标,而其中较为普遍的可能为:

1.负责清洗消毒工作的人员对清洗消毒的频率及要求执行不到位或不了解,可能出现生产环境卫生状况不良,生产设备连续使用未进行清洗消毒,对生产设备清洗不干净或消毒不严,产生微生物滞留和滋生等情况造成食品污染伊红美蓝鉴别大肠杆菌颜色变化,进而导致菌落总数超标。
2.生产操作人员不按生产要求进行操作。如:负责杀菌工序的人员对杀菌的参数及要求执行不到位或不了解,可能导致杀菌不彻底。
3.员工培训不到位,缺乏卫生意识。如:加工过程中生熟不分,发生交叉污染,进而导致菌落总数超标。想要解决人员因素导致的菌落总数超标,方法就是人员提升培训,严格规范作业流程,提高员工的卫生意识及技术水平才有可能达到我们想要的效果。
(二)设备
设备设施的能力和状态也可能与菌落总数超标有关。此处以食品工厂中杀菌设备和包装机为例。包装后需进行杀菌的产品,若杀菌设备性能不足、温度计未校准导致杀菌不彻底都有可能引起菌落总数超标。针对杀菌设备,我们可以通过做热力分布和热穿透测试,验证杀菌釜的性能以及定期使用温度记录仪,跟踪杀菌过程产品温度的变化、做好温度计的校准等工作来避免菌落总数超标。
同样的,包装机若密封性能不足,可能导致产品在杀菌和后期的贮存过程中出现被污染的情况。针对包装机,我们可以通过建立包装机性能验证,确保密封性良好,同时做好内包车间和包装机的清洁卫生来减少菌落总数超标的可能。
(三)物料
食品生产中的物料主要包括各种原辅料、内包材、生产用水和冰等,若各种料原始微生物含量较高,还是有增加后期产品菌落总数超标的风险;因此我们应有针对性的对原辅料包材进行评估,制定一定的验收要求并对原辅料包材进行对应的检测,并在贮存和加工过程中做好温湿度控制和环境管理。
另外,内包材在使用前还可考虑采取紫外灯或臭氧进行消毒。对于生产用水和冰,可以采取每周一次的频率对其微生物状况进行验证。
(四)方法
方法主要指的各种有关微生物措施制定的合理性。如:设备设施、环境、人员清洗消毒的频率及方法是否合理?杀菌公式的设定是否合理?生产过程中环境温湿度的控制是否合理?食品储存和运输中设定的条件(如冷链)是否合理等。
这种情况,我们可以采取的措施就是验证。通过对事前事后进行微生物实验,将得出的数据进行比对,确认方法是否可行。除此之外,我们还可以通过调整一定的参数并采集实验数据来对方法进行优化,进而确定最合适的方法。
(五)环境
从原辅料的运输、贮存、加工成成品以及销售等各个环节场所的不当,都有可能导致产品菌落总数超标。如:包装车间卫生不当、生产环境温湿度控制不当、废料间卫生间位置设施不当等。
针对环境,我们可以采取的措施是合理考虑各个场所的布局、严格控制各个环节的温湿度以及持续保持各个场所的卫生等措施。
(六)流通
若在流通环节检出多种食品存在菌落总数超标的情况,则问题极有可能是销售方未按照规定要求存储、摆放食品,比如个别超市不具备低温冷藏设施却销售需冷藏的食品,有的食品标签标注储存条件为避光,销售者却将食品置于阳光直射条件下等。
———END———
限 时 特 惠: 本站每日持续更新海量各大内部创业教程,一年会员只需98元,全站资源免费下载 点击查看详情
站 长 微 信: Lgxmw666





